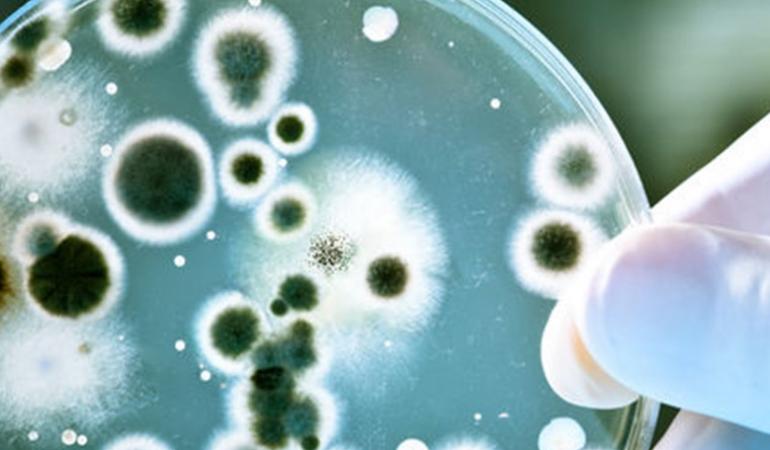

Publicatiedatum 25-05-2021 | 09:35
In dit vernieuwde kennisbericht ligt de focus bij het risico op humane besmetting via de veehouderij, waarbij tevens de context met de andere bronnen (potentiële reservoirs van resistente bacteriën) beknopt wordt aangeven, net zoals in de voorgaande versie.
Een belangrijk risico van antibioticumgebruik is dat bacteriën er ongevoelig voor kunnen worden. Ze zijn dan resistent en antibiotica zullen voortaan minder goed werken, waardoor mensen niet (goed) herstellen. Het is bekend dat hoe meer antibiotica worden gebruikt, hoe groter de kans is dat bacteriën resistent worden.
Belangrijkste conclusies:
- Sinds 2009 is het antibioticumgebruik in de veehouderij met bijna 70% gedaald. Het beleid verschuift nu steeds meer naar verdere afname bij de resterende hooggebruikers.
- Cruciale antibiotica voor mensen worden nauwelijks nog gebruikt in de veehouderij. Dit heeft de kans op problematische resistenties bij mensen vanuit onze veehouderijen heel klein gemaakt.
- ESBL (Extended Spectrum Beta-Lactamase. Dit is een enzym dat bepaalde soorten antibiotica (penicillines en cefalosporines) kan afbreken. ) is voor met name veehouders, hun gezinsleden en hun werknemers een belangrijk aandachtspunt (vooral via direct contact met dieren).
- Het is belangrijk om waakzaam te blijven op verspreiding van resistente bacteriën zoals v-MRSA (Meticilline-resistente Staphylococcus aureus (MRSA) staat bekend als de 'ziekenhuisbacterie'
) naar de omgeving. De jaarlijkse Nethmap/MARAN (Monitoring of Antimicrobial Resistance and Antibiotic Usage in Animals in the Netherlands
) rapportage voorziet hier in belangrijke mate in.